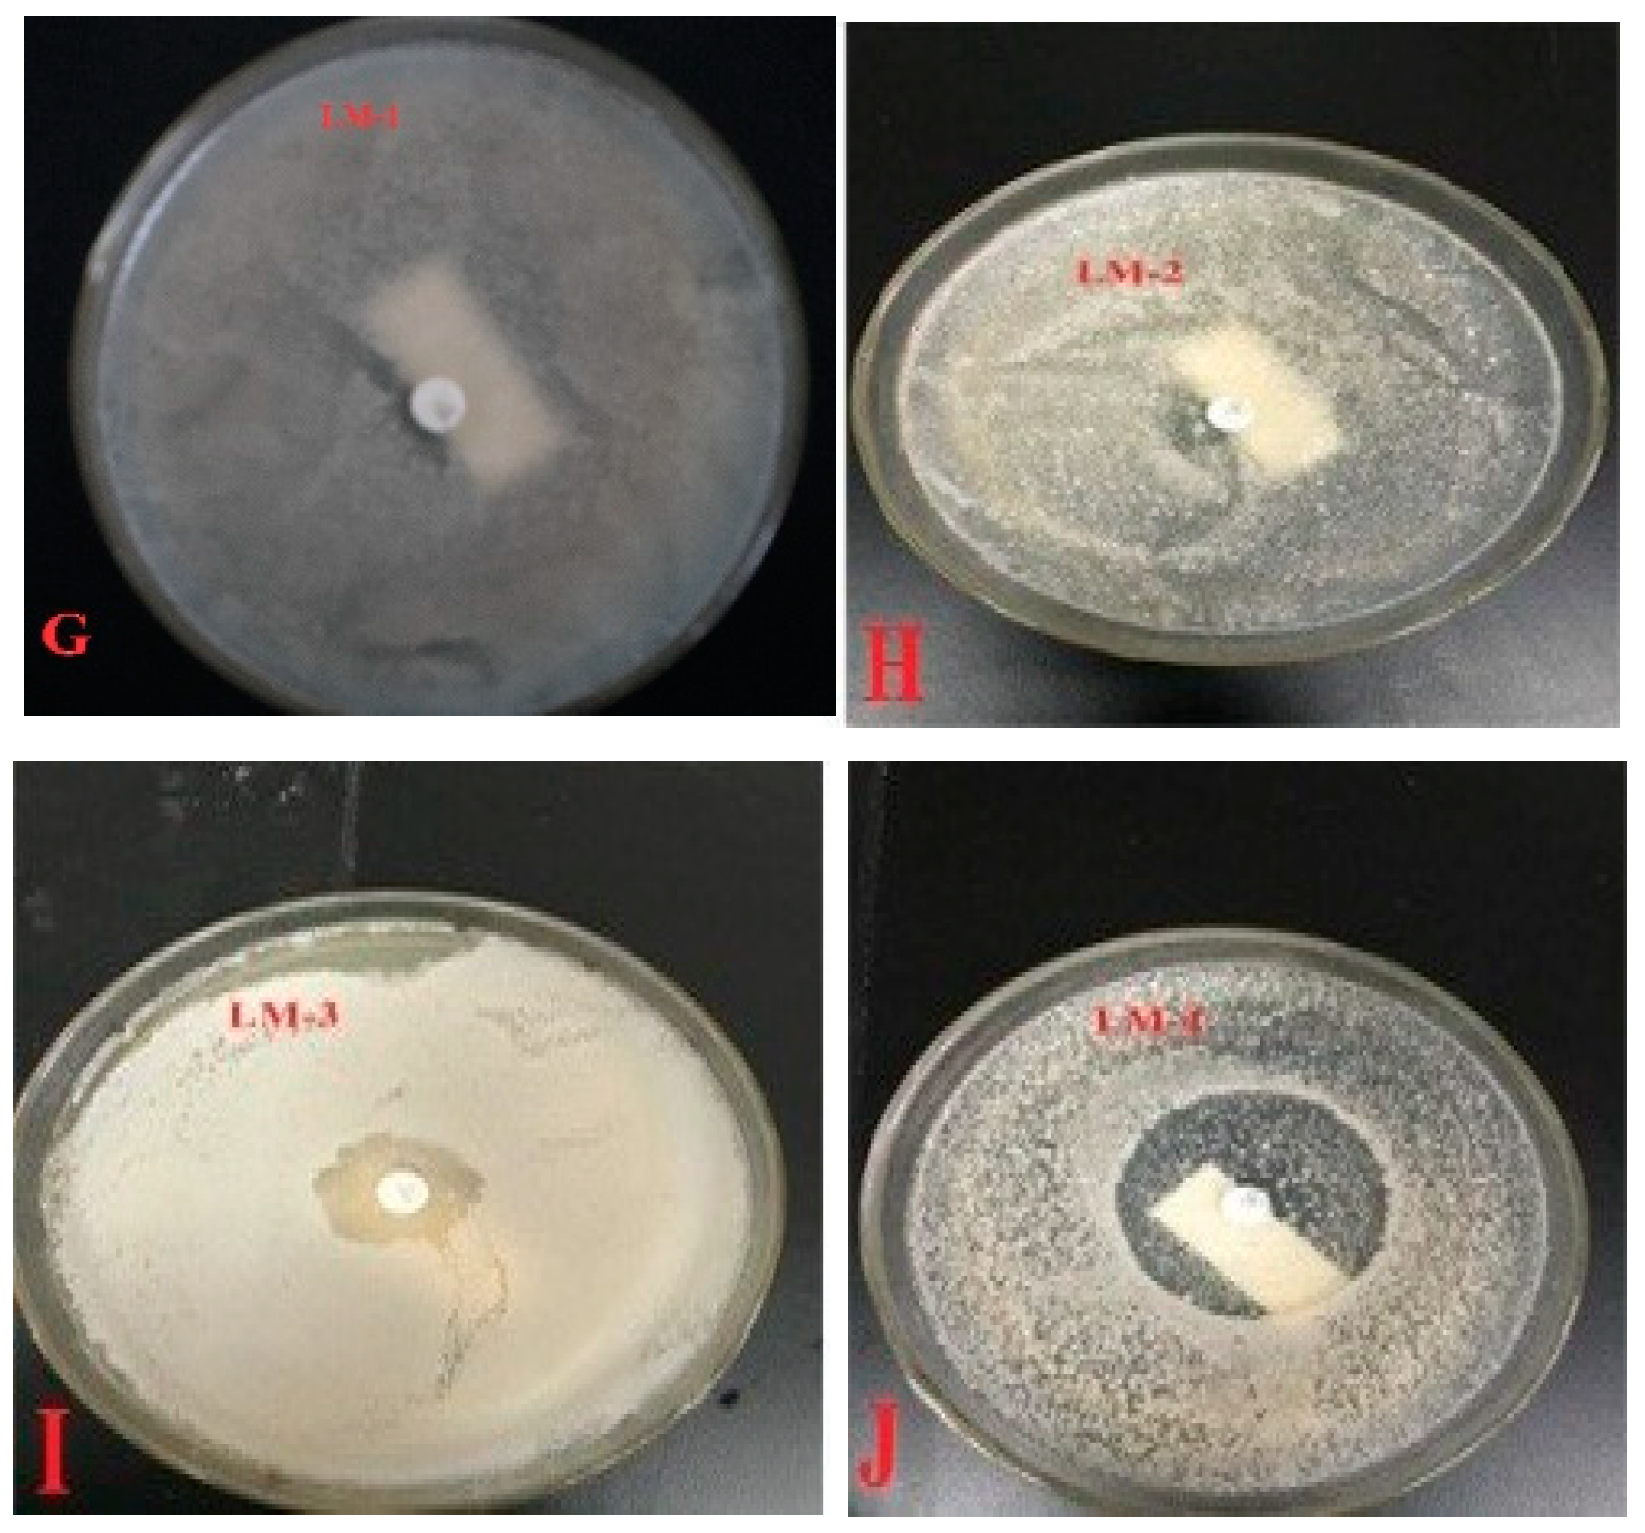

Isolation, Screening, and Characterization of Antibiotic-Degrading Bacteria for Penicillin V Potassium (PVK) from Soil on a Pig Farm
Abstract
:1. Introduction
2. Materials and Methods
2.1. Collection of Soil on Pig Farm
2.2. Reagents and Culture Media
2.3. Enrichment and Acclimatization of Bacterial Strains
2.4. Isolation and Purification of Enriched Bacterial Strains
2.5. Qualitative Screening of PVK-Degrading Bacteria
2.6. Qquantitative Evalatution of PVK-Degrading Bacteria
2.7. Morphological Observation of Isolated Strains
2.8. Gene Sequencing and Phylogenetic Analysis of Isolated Strains
3. Results and Discussion
3.1. Isolation and Initial Screening of PVK-Degrading Bacteria
3.2. TMSUS Measurements
3.3. Morphological Features of Isolated Strains
3.4. Gene Sequencing and Phylogenetic Analysis of Two PVK-Degrading Isolates
4. Conclusions
Supplementary Materials
Author Contributions
Funding
Conflicts of Interest
References
- Carvalho, I.T.; Santos, L. Antibiotics in the aquatic environments: A review of the European scenario. Environ. Int. 2016, 94, 736–757. [Google Scholar] [CrossRef] [PubMed]
- Bloem, E.; Albihn, A.; Elving, J.; Hermann, L.; Lehmann, L.; Sarvi, M.; Schaaf, T.; Schick, J.; Turtol, E.; Ylivainio, K. Contamination of organic nutrient sources with potential and treatment options for the production of sustainable fertilizers: A review. Sci. Total Environ. 2017, 607, 225–242. [Google Scholar] [CrossRef] [PubMed]
- Ramaswamy, J.; Prasher, S.O.; Patel, R.M.; Hussain, S.A.; Barrington, S.F. The effect of composting on the degradation of a veterinary pharmaceutical. Bioresour. Technol. 2010, 101, 2294–2299. [Google Scholar] [CrossRef] [PubMed]
- Gonzalez Ronquillo, M.; Angeles Hernandez, J.C. Antibiotic and synthetic growth promoters in animal diets: Review of impact and analytical methods. Food Control 2017, 72, 255–267. [Google Scholar] [CrossRef]
- Vikesland, P.J.; Pruden, A.; Alvarez, P.J.; Aga, D.; Burgmann, H.; Li, X.D.; Manaia, C.M.; Nambi, I.; Wigginton, K.; Zhang, T. Toward a comprehensive strategy to mitigate dissemination of environmental sources of antibiotic resistance. Int. J. Environ. Sci. Technol. 2017, 51, 13061–13069. [Google Scholar] [CrossRef]
- Zhou, X.F.; Liu, D.D.; Zhang, Y.L.; Chen, J.B.; Chu, H.Q.; Qian, Y.J. Degradation mechanism and kinetic modeling for UV/peroxydisulfate treatment of penicillin antibiotics. Chem. Eng. J. 2018, 341, 93–101. [Google Scholar] [CrossRef]
- Wang, J.; Ben, W.; Yang, M.; Zhang, Y.; Qiang, Z.M. Dissemination of veterinary antibiotics and corresponding resistance genes from a concentrated swine feedlot along the waste treatment paths. Environ. Int. 2016, 92–93, 317–323. [Google Scholar] [CrossRef]
- Wu, M.; Que, C.; Tang, L.; Xu, H.; Xiang, J.J.; Wang, J.J.; Shi, W.Y.; Xu, G. Distribution, fate, and risk assessment of antibiotics in five wastewater treatment plants in Shanghai, China. Environ. Sci. Pollut. Res. Int. 2016, 23, 18055–18063. [Google Scholar] [CrossRef]
- Liu, Q.Q.; Li, M.; Liu, X.; Zhang, Q.; Liu, R.; Wang, Z.L.; Shi, X.T.; Quan, J.; Shen, X.H.; Zhang, F.W. Removal of sulfamethoxazole and trimethoprim from reclaimed water and the biodegradation mechanism. Front. Env. Sci. Eng. 2018, 12, 6. [Google Scholar] [CrossRef]
- Forsberg, K.J.; Bin, W.; Selleck, E.M.; Sommer, M.O.A.; Dantas, G. The shared antibiotic resistome of soil bacteria and human pathogens. Science 2012, 337, 1107–1111. [Google Scholar] [CrossRef]
- Leung, H.W.; Minh, T.B.; Murphy, M.B.; Lam, J.C.W.; So, M.K.; Martin, M.; Lam, P.K.S.; Richardson, B.J. Distribution, fate, and risk assessment of antibiotics in sewage treatment plants in Hong Kong, South China. Environ. Int. 2012, 42, 1–9. [Google Scholar] [CrossRef] [PubMed]
- Ben, W.; Qiang, Z.; Pan, X.; Nie, Y. Degradation of veterinary antibiotics by ozone in swine wastewater pretreated with sequencing batch reactor. J. Environ. Eng. 2011, 138, 272–277. [Google Scholar] [CrossRef]
- Zhao, J.; Zhang, Z.H.; Duan, H.Y.; Yu, R.; Wang, C.Y. Isolation and identification of a penicillin-degrading strain during composting of penicillin bacteria residue. Res. Environ. Sci. 2016, 29, 271–278. [Google Scholar] [CrossRef]
- Adel, A.A.S.; Lalung, J.; Eoman, E.A.; Bala, J.D.; Norli, I. Removal of heavy metals and antibiotics from treated sewage effluent by bacteria. Clean Technol. Environ. Policy 2015, 17, 2101–2123. [Google Scholar] [CrossRef]
- Al-Gheethi Adel, A.S.; Ismail, N. Biodegradation of pharmaceutical wastes in treated sewage effluents by bacillus subtilis 1556 WTNC. Environ. Processes 2014, 1, 459–481. [Google Scholar] [CrossRef]
- Liu, J.Z.; Wang, Q.; Yan, J.B.; Qin, X.R. Isolation and characterization of novel phenol degrading bacterial strain WUST-C1. Ind. Eng. Chem. Res. 2013, 52, 258–265. [Google Scholar] [CrossRef]
- Feng, L.Z. Research on the Biochemical Treatment of Penicillin Wastewater; Northeastern University: Shenyang, China, 2009. [Google Scholar]
- Fu, H.; Liu, H.L.; Wang, P. Screening and identification of Penicillin-degrading bacteria and its degradation effects. Environ. Prot. Sci. 2015, 41, 42–45. [Google Scholar]
- Liu, N.D.; Lin, G.; Zhang, Q. Determination of benzylpenicillin sodium by the thiol mercuric salt UV spectrophotometry. Chin. J. Hosp. Pharm. 1991, 11, 82–83. [Google Scholar]
- Kumar, M.; Leon, V.; Materano, A.D.; Ilzins, O.A. A halotolerant and theromtolerant Bacillus sp. Degrades hydrocarbons and produces tensio-active emulsifying agent. World J Microb. Biot. 2007, 23, 211–220. [Google Scholar] [CrossRef]
- Thompson, J.D.; Higgins, D.G.; Gibson, T.J. CLUSTALW: Improving the sensitivity of progressive multiple sequence alignment through sequence weighting, position-specific gap penalties and weight matrix choice. Nucleic Acids Res. 1994, 22, 4673–4680. [Google Scholar] [CrossRef]
- Saitou, N.; Nei, M. The neighbor-joining method: A new method for reconstructing phylogenetic trees. Mol. Biol. Evol. 1987, 4, 406–425. [Google Scholar] [CrossRef] [PubMed]
- Chen, R.D.; Wu, B.L. Discussion about antibiotic resistance mechanisms. Fujian J. Anim. Husbandary Vet. 2006, 28, 59–60. [Google Scholar]
- Yang, J.; Zhang, M.Y.; Zhang, Q.F.; Yang, P.; Liu, Q.W.; Li, Y.G.; Zhang, L.H.; Dong, J.H. Isolation, identification, and herbicidal activity of Bacillus cereus XG1. J. Agric. Univ. Hebei 2016, 39, 81–86. [Google Scholar]
- Peng, H.N. Screening and Molecular Identification of Bacteriostatic Bacillus Pumilus 4D-14, Probiotic Development and Application Research; Ocean University of China: Shandong, China, 2013. [Google Scholar]
- Wang, W.D.; Lin, W.; Qin, Y.; Zhang, L.K.; Li, J.X.; Li, H.R.; Zhang, T.T. Performance and mechanism of Th (IV) adsorption from aqueous solution by Bacillus cereus WHY-2. J. Chin. Soc. Rare Earths 2018, 36, 746–754. [Google Scholar]
- Leng, Y.F. Characteristics and mechanism of Tetracycline Degradation by microorganism; China University of Geosciences (Wuhan): Hubei, China, 2017. [Google Scholar]
- Liu, Y.W.; Li, Z.J.; Feng, Y.; Cheng, D.M.; Hu, H.Y.; Zhang, W.J. Research progress in microbial degradation of antibiotics. J. Agro-Environ. Sci. 2016, 35, 212–224. [Google Scholar]

| Strains | PVK Concentration of Control Group (μg/mL, Mean ± SD) | ODcontrol (Mean ± SD) | PVK Concentration of Test Group (μg/mL, Mean ± SD) | ODtest (Mean ± SD) | RD (Mean ± SD) |
|---|---|---|---|---|---|
| LM-1 | 96.28 ± 2.55 | 0.57 ± 0.015 | 33.50 ± 5.78 | 0.18 ± 0.055 | 0.68 ± 0.091 |
| LM-2 | 85.17 ± 1.67 | 0.50 ± 0.021 | 29.06 ± 12.62 | 0.17 ± 0.076 | 0.66 ± 0.14 |
| LM-3 | 84.61 ± 12.50 | 0.51 ± 0.031 | 52.94 ± 4.84 | 0.32 ± 0.031 | 0.38 ± 0.095 |
© 2019 by the authors. Licensee MDPI, Basel, Switzerland. This article is an open access article distributed under the terms and conditions of the Creative Commons Attribution (CC BY) license (http://creativecommons.org/licenses/by/4.0/).
Share and Cite
Yang, X.; Li, M.; Guo, P.; Li, H.; Hu, Z.; Liu, X.; Zhang, Q. Isolation, Screening, and Characterization of Antibiotic-Degrading Bacteria for Penicillin V Potassium (PVK) from Soil on a Pig Farm. Int. J. Environ. Res. Public Health 2019, 16, 2166. https://doi.org/10.3390/ijerph16122166
Yang X, Li M, Guo P, Li H, Hu Z, Liu X, Zhang Q. Isolation, Screening, and Characterization of Antibiotic-Degrading Bacteria for Penicillin V Potassium (PVK) from Soil on a Pig Farm. International Journal of Environmental Research and Public Health. 2019; 16(12):2166. https://doi.org/10.3390/ijerph16122166
Chicago/Turabian StyleYang, Xuanjiang, Miao Li, Panpan Guo, Hualong Li, Zelin Hu, Xianwang Liu, and Qiang Zhang. 2019. "Isolation, Screening, and Characterization of Antibiotic-Degrading Bacteria for Penicillin V Potassium (PVK) from Soil on a Pig Farm" International Journal of Environmental Research and Public Health 16, no. 12: 2166. https://doi.org/10.3390/ijerph16122166
APA StyleYang, X., Li, M., Guo, P., Li, H., Hu, Z., Liu, X., & Zhang, Q. (2019). Isolation, Screening, and Characterization of Antibiotic-Degrading Bacteria for Penicillin V Potassium (PVK) from Soil on a Pig Farm. International Journal of Environmental Research and Public Health, 16(12), 2166. https://doi.org/10.3390/ijerph16122166




